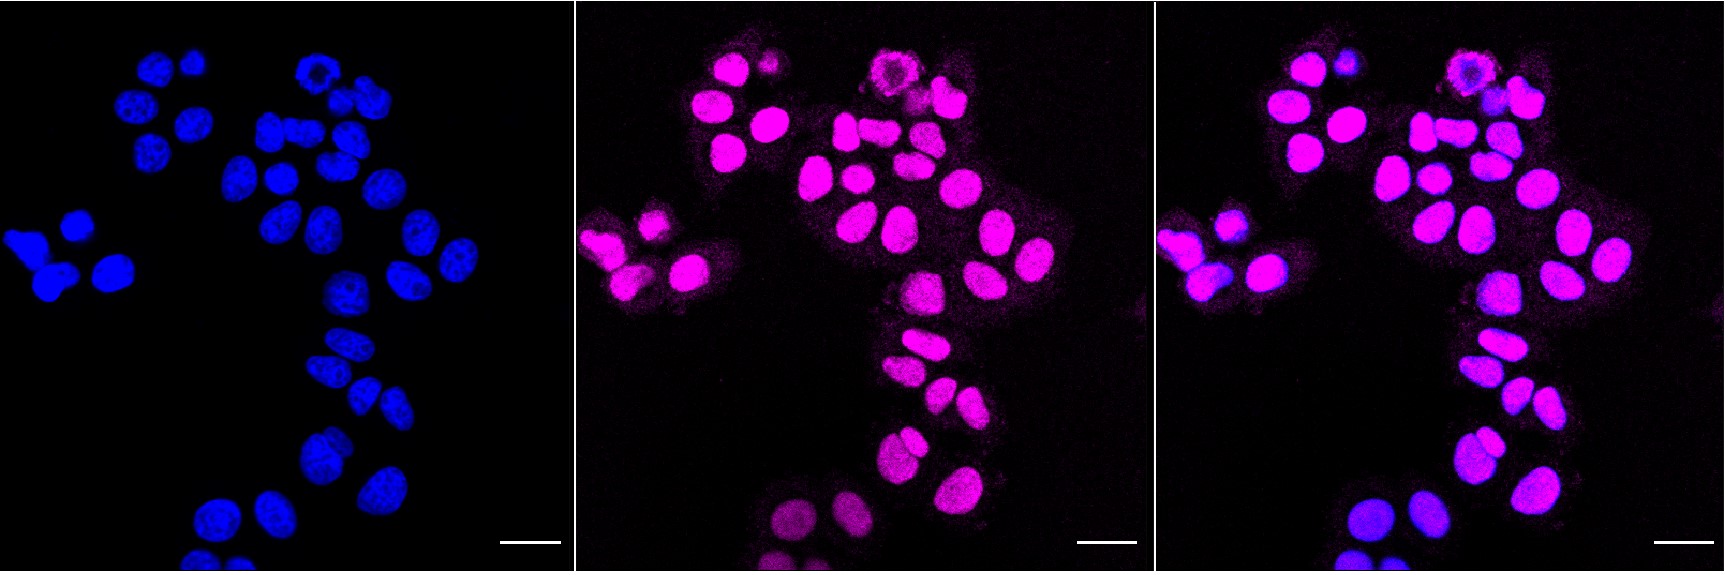

HLTF Recombinant Monoclonal Antibody
-
中文名稱:HLTF Recombinant Monoclonal Antibody
-
貨號:CSB-RA108039A0HU
-
規格:¥1320
-
圖片:
-
Flow cytometric analysis of helicase like transcription factor expression in HepG2 cells using helicase like transcription factor antibody. Green, isotype control; red, helicase like transcription factor.
-
Immunocytochemical staining of HepG2 cells with Helicase like transcription factor antibody. Nuclei were stained blue with DAPI; Helicase like transcription factor was stained magenta with Alexa Fluor? 647. Images were taken using Leica stellaris 5. Protein abundance based on laser Intensity and smart gain: High. Scale bar, 20 μm.
-
Western blotting analysis using helicase like transcription factor antibody. Total cell lysates (30 μg) from various cell lines were loaded and separated by SDS-PAGE. The blot was incubated with helicase like transcription factor antibody and HRP-conjugated goat anti-rabbit secondary antibody respectively.
-
-
其他:
產品詳情
-
Uniprot No.:
-
基因名:HLTF
-
別名:HLTF; Helicase Like Transcription Factor; HIP116A; RNF80; SMARCA3; SNF2L3; HLTF1; SWI/SNF Related, Matrix Associated, Actin Dependent Regulator Of Chromatin, Subfamily A, Member 3; SWI/SNF-Related Matrix-Associated Actin-Dependent Regulator Of Chromatin Subfamily A Member 3; RING-Type E3 Ubiquitin Transferase HLTF; Sucrose Nonfermenting Protein 2-Like 3; Helicase-Like Transcription Factor; RING Finger Protein 80; HIP116; ZBU1; DNA-Binding Protein/Plasminogen Activator Inhibitor-1 Regulator; DNA-Binding Protein/Plasminogen Activator Inhibitor 1 Regulator; Sucrose Nonfermenting-Like 3; SNF2-Like 3; EC 2.3.2.27; EC 3.6.4.-; EC 3.6.1
-
反應種屬:Human
-
免疫原:Recombinant Human HLTF protein
-
免疫原種屬:Homo sapiens (Human)
-
標記方式:Non-conjugated
-
克隆類型:Monoclonal
-
抗體亞型:Rabbit IgG
-
純化方式:Affinity-chromatography
-
克隆號:3D2
-
濃度:It differs from different batches. Please contact us to confirm it.
-
保存緩沖液:Rabbit IgG in PBS (pH 7.4) containing 50% glycerol, and 0.02% sodium azide.
-
產品提供形式:Liquid
-
應用范圍:ELISA, WB, FC, ICC
-
推薦稀釋比:
Application Recommended Dilution WB 1:1000-1:5000 FC 1:200-1:2000 ICC 1:100-1:1000 -
Protocols:
-
儲存條件:Upon receipt, store at -20°C or -80°C. Avoid repeated freeze.
-
貨期:Basically, we can dispatch the products out in 1-3 working days after receiving your orders. Delivery time maybe differs from different purchasing way or location, please kindly consult your local distributors for specific delivery time.
-
用途:For Research Use Only. Not for use in diagnostic or therapeutic procedures.
相關產品
靶點詳情
-
功能:Has both helicase and E3 ubiquitin ligase activities. Possesses intrinsic ATP-dependent nucleosome-remodeling activity; This activity may be required for transcriptional activation or repression of specific target promoters. These may include the SERPINE1 and HIV-1 promoters and the SV40 enhancer, to which this protein can bind directly. Plays a role in error-free postreplication repair (PRR) of damaged DNA and maintains genomic stability through acting as a ubiquitin ligase for 'Lys-63'-linked polyubiquitination of chromatin-bound PCNA.
-
基因功能參考文獻:
- Data suggest that HIV-1 vpr mediates polyubiquitination of HLTF by directly loading it onto C-terminal WD40 domain of DCAF1 in complex the CRL4, an E3 ubiquitin ligase. (vpr = vpr gene product of Human immunodeficiency virus 1; HLTF = human helicase like transcription factor; DCAF1 = human Vpr (HIV-1) binding protein; CRL4 = human E3 ubiquitin ligase CRL4) PMID: 29079575
- A low WT HLTF expression with a high I21R HLTF expression is associated with a poor disease-free survival PMID: 29661164
- the present study does not provide any strong evidence that PAI-1 gene variants are implicated in the risk of DR or the development of DR during T2DM course. PMID: 28632032
- A large number of SNF2 family, DNA and ATP-dependent motor proteins are needed during transcription, DNA replication, and DNA repair to manipulate protein-DNA interactions and change DNA structure. SMARCAL1, ZRANB3, and HLTF are three related members of this family with specialized functions that maintain genome stability during DNA replication. [review] PMID: 28954549
- depletion of SMARCAL1, a SNF2-family DNA translocase that remodels stalled forks, restores replication fork stability and reduces the formation of replication stress-induced DNA breaks and chromosomal aberrations in BRCA1/2-deficient cells. In addition to SMARCAL1, other SNF2-family fork remodelers, including ZRANB3 and HLTF, cause nascent DNA degradation and genomic instability PMID: 29053959
- HIV-1 vpr reprograms CRL4(DCAF1) E3 to direct HLTF for proteasome-dependent degradation independent from previously reported Vpr interactions with base excision repair enzyme uracil DNA glycosylase (UNG2) and crossover junction endonuclease MUS81, which Vpr also directs for degradation via CRL4(DCAF1) E3. PMID: 27335459
- Fasudil reduced LPS-mediated TF and PAI-1 expression and activity in PBMCs. These effects may partially be relevant to the clinical benefits of fasudil in the treatment of CAPD patients. PMID: 27756191
- HLTF is degraded in lymphocytic cells and macrophages infected with Vpr-expressing HIV-1. Our results reveal a previously unidentified strategy for HIV-1 to antagonize DNA repair in host cells. PMID: 27114546
- HLTF expression is altered in various cancers via two mechanisms: gene silencing through promoter hypermethylation or alternative mRNA splicing, which leads to the expression of truncated proteins that lack DNA repair domains. [review] PMID: 26472339
- HLTF promotes the filling-in of gaps left opposite damaged DNA during replication, and this postreplication repair function depends on its HIRAN domain. PMID: 26350214
- Findings indicate a mechanism of helicase-like transcription factor HLTF-mediated fork reversal and suggest the requirement for distinct fork remodeling activities in the cell. PMID: 26051180
- These results suggest that the HIRAN domain functions as a sensor to the 3'-end of the primer strand at the stalled replication fork and that the domain facilitates fork regression. PMID: 25858588
- Study demonstrates a correlation between HLTF expression level and thyroid neoplastic progression where three truncated forms are detected in thyroid carcinoma. PMID: 25005870
- We were able to provide evidence that methylation of HLTF and especially HPP1 detected in serum is strongly correlated with cell death in CRC using LDH as surrogate marker PMID: 24708595
- Results demonstrate that loss of HLTF function promotes the malignant transformation of intestinal or colonic adenomas to carcinomas by inducing genomic instability. PMID: 22452792
- results delineate a previously unknown USP7-HLTF-PCNA molecular network controlling DNA damage response PMID: 21845734
- HLTF can displace a broad spectrum of proteins such as replication protein A (RPA), PCNA, and replication factor C (RFC), thereby providing the first example for a protein clearing activity at the stalled replication fork. PMID: 21795603
- HLTF and SHPRH suppress mutagenesis in a damage-specific manner, preventing mutations induced by UV rays and methyl methanesulfonate. PMID: 21396873
- results suggest that HLTF is involved in DNA repair and apoptosis in cancer cells, which might represent a target for gene therapies of human cancer PMID: 20535496
- this is the first report identifying the regulatory mechanism of HLTF by CHFR, suggesting that CHFR-mediated downregulation of HLTF may help protect against cancer. PMID: 20388495
- HLTF can promote error-free replication of damaged DNA and support a role for HLTF in preventing mutagenesis and carcinogenesis, providing thereby for its potential tumor suppressor role. PMID: 19948885
- These results suggest that HLTF promoter hypermethylation is frequently demonstrated in human gastric cancer, and inactivation of HLTF or the chromatin-remodeling complex may play a crucial role in gastric carcinogenesis. PMID: 12766908
- Acetylation of histones H3 and H4 in the 5' CpG island of the HLTF gene were inversely associated with DNA methylation status. PMID: 12901794
- Methylation helicase-like transcription factor is associated with advanced esophageal squamous cell carcinoma PMID: 17094449
- HLTF activation was recently linked to the initial steps of carcinogenesis in an experimental model of estrogen-induced kidney tumor. [REVIEW] PMID: 18034322
- HLTF physically interacts with the Rad6-Rad18 and Mms2-Ubc13 ubiquitin-conjugating enzyme complexes and promotes the Lys-63-linked polyubiquitination of proliferating cell nuclear antigen at its Lys-164 residue. PMID: 18316726
- Splice arrays and RT-PCR showed that although most splice variants in RUSH and ATP11B are conserved in human and rabbit, the RFBP isoform is specific to rabbit. PMID: 18584949
- HLTF and SHPRH are functional homologues of yeast Rad5 that cooperatively mediate PCNA polyubiquitination and maintain genomic stability. PMID: 18719106
- There is an association between the presence of helicase-like transcription factor and neoplastic progression of hypopharyngeal and laryngeal squamous cell carcinomas. PMID: 18825407
- Hypopharyngeal squamous cell carcinomas presenting high levels of HLTF have a worse prognosis. PMID: 19614770
- biochemical characterisation of cellular HLTF is described. PMID: 19723507
- HLTF/SMARCA3, a member of SWI/SNF family, is a common target for methylation and epigenetic gene silencing in colon cancer and a candidate colon cancer suppressor gene. PMID: 11904375
- SMARCA3 is the human gene for RUSH transcription factors (U66564, U66565; Mol Endocrinol, 1996, 10:1335-1349). A binding partner has been cloned and characterized (AF236061; JBC, 2001, 276:3641-3649). PMID: 11058586
顯示更多
收起更多
-
亞細胞定位:Cytoplasm. Nucleus. Nucleus, nucleolus. Nucleus, nucleoplasm.
-
蛋白家族:SNF2/RAD54 helicase family, RAD16 subfamily
-
組織特異性:Expressed in brain, heart, kidney, liver, lung, pancreas, placenta and skeletal muscle.
-
數據庫鏈接:
Most popular with customers
-
-
YWHAB Recombinant Monoclonal Antibody
Applications: ELISA, WB, IHC, IF, FC
Species Reactivity: Human, Mouse, Rat
-
Phospho-YAP1 (S127) Recombinant Monoclonal Antibody
Applications: ELISA, WB, IHC
Species Reactivity: Human
-
-
-
-
-